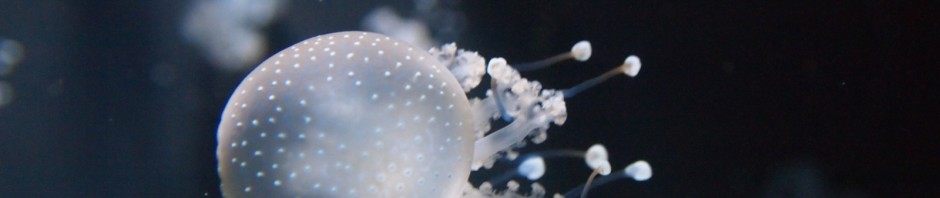
Fische und anderes Getier ...

… aus dem berliner Zooaquarium
13. September 2013
Fische und anderes Getier …
Lucia
Administrator
Ich studiere Physik in Erlangen, mit Schwerpunkt Astro- und Astroteilchenphysik. Daneben engagiere ich mich für Projekte, in denen ich meine Faszination für Wissenschaft weitergeben kann. Neben der Physik bin ich gerne sportlich aktiv, beim Triathlon, Bergsteigen oder Skilanglauf. Außerdem fotografiere ich gerne. Persönlich Webseite: Lukatha.de

Kommentare von Lucia